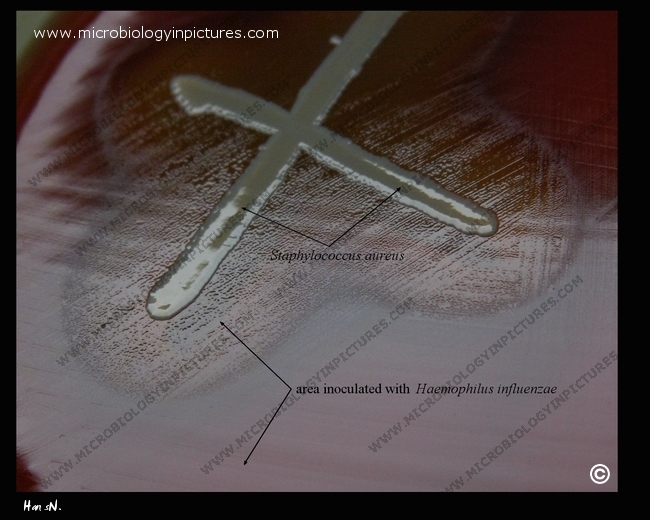

Haemophilus influenzae will grow in the hemolytic zone of Staphylococcus aureus on blood agar plates. The hemolysis of erythrocytes by S. aureus releases nutrients vital to the growth of H. influenzae (NAD, factor V). The NAD diffuses into the surrounding medium and stimulates the growth of Haemophilus influenzae in the vicinity of the staphylococcus. H. influenzae will not grow outside the hemolytic zone of Staphylococcus aureus. This is known as satelliting. For Haemophilus spp., the satellite test substitutes for the V factor test.